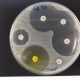

Naiara recibe su nuevo corazón en un trasplante único en el mundo
Pandemia de infecciones resistentes a los antibióticos
18 mayo, 2021
Investigadores aragoneses desarrollan el primer test rápido para covid en mascotas
18 mayo, 2021El Hospital Gregorio Marañón ha realizado el primer trasplante cardíaco en parada a un bebé incompatible con el donante
El hospital madrileño Gregorio Marañón ha llevado a cabo con éxito el primer trasplante del mundo de un corazón infantil en parada, que fue recibido por un bebé de dos meses y con incompatibilidad sanguínea con su donante.
También es un caso “único en el mundo” porque donante y receptor estaban en centros distintos y el trasplante se realizó tras un periodo prolongado de isquemia fría durante el traslado, que tuvo que realizarse por vía aérea, según pone en valor la Comunidad de Madrid en un comunicado emitido este lunes.
El Hospital General Universitario Gregorio Marañón comenzó en 2018 un programa, primero en España, que le permite realizar trasplantes de corazón en niños con grupo de sangre incompatible, a lo que se suma que este es el primer caso en el país en que el injerto cardíaco de donante en asistolia se realiza a un bebé tan pequeño.
En el procedimiento utilizado, el corazón del donante fallecido se recuperó antes de su extracción a través de un sistema de circulación extracorpórea, que permite mantener oxigenados los órganos susceptibles de trasplante y valorar el funcionamiento cardiaco, explica la Comunidad.
Estos trasplantes extraordinarios, entre personas con grupo sanguíneo incompatible y con un corazón en parada, era anteriormente “inviable”, pero ahora ayuda a “aumentar significativamente” las posibilidades de “recuperar un corazón para los niños más pequeños”, los bebés de apenas unos meses, para los que hay “pocas donaciones”.
Así lo explica el jefe de Cirugía Cardíaca Infantil del Gregorio Marañón, Juan Miguel Gil Jaurena, quien añade que la complejidad radica en “recuperar el latido del corazón, que viene parado”, y matiza que, tras su recuperación, los pasos a seguir son iguales que en una extracción tradicional.
La situación de Naiara previa a la operación era muy compleja, porque los problemas de corazón que se le detectaron en la gestación obligaron a adelantar el parto y, después, esperar a que el resto de órganos “maduraran lo suficiente” para plantearse la posibilidad de que la niña entrara en lista de trasplante.
Ahora su caso “da mayores esperanzas” a las familias con niños con enfermedades muy graves, resaltan desde la Comunidad de Madrid.
Por su parte, la directora general de la Organización Nacional de Trasplantes, Beatriz Domínguez-Gil, pone en valor el papel de la familia del donante, que, en los peores momentos de su vida, “no dudaron en acceder a la donación”, al mismo tiempo que destaca la cooperación entre los equipos de los dos centros implicados.




